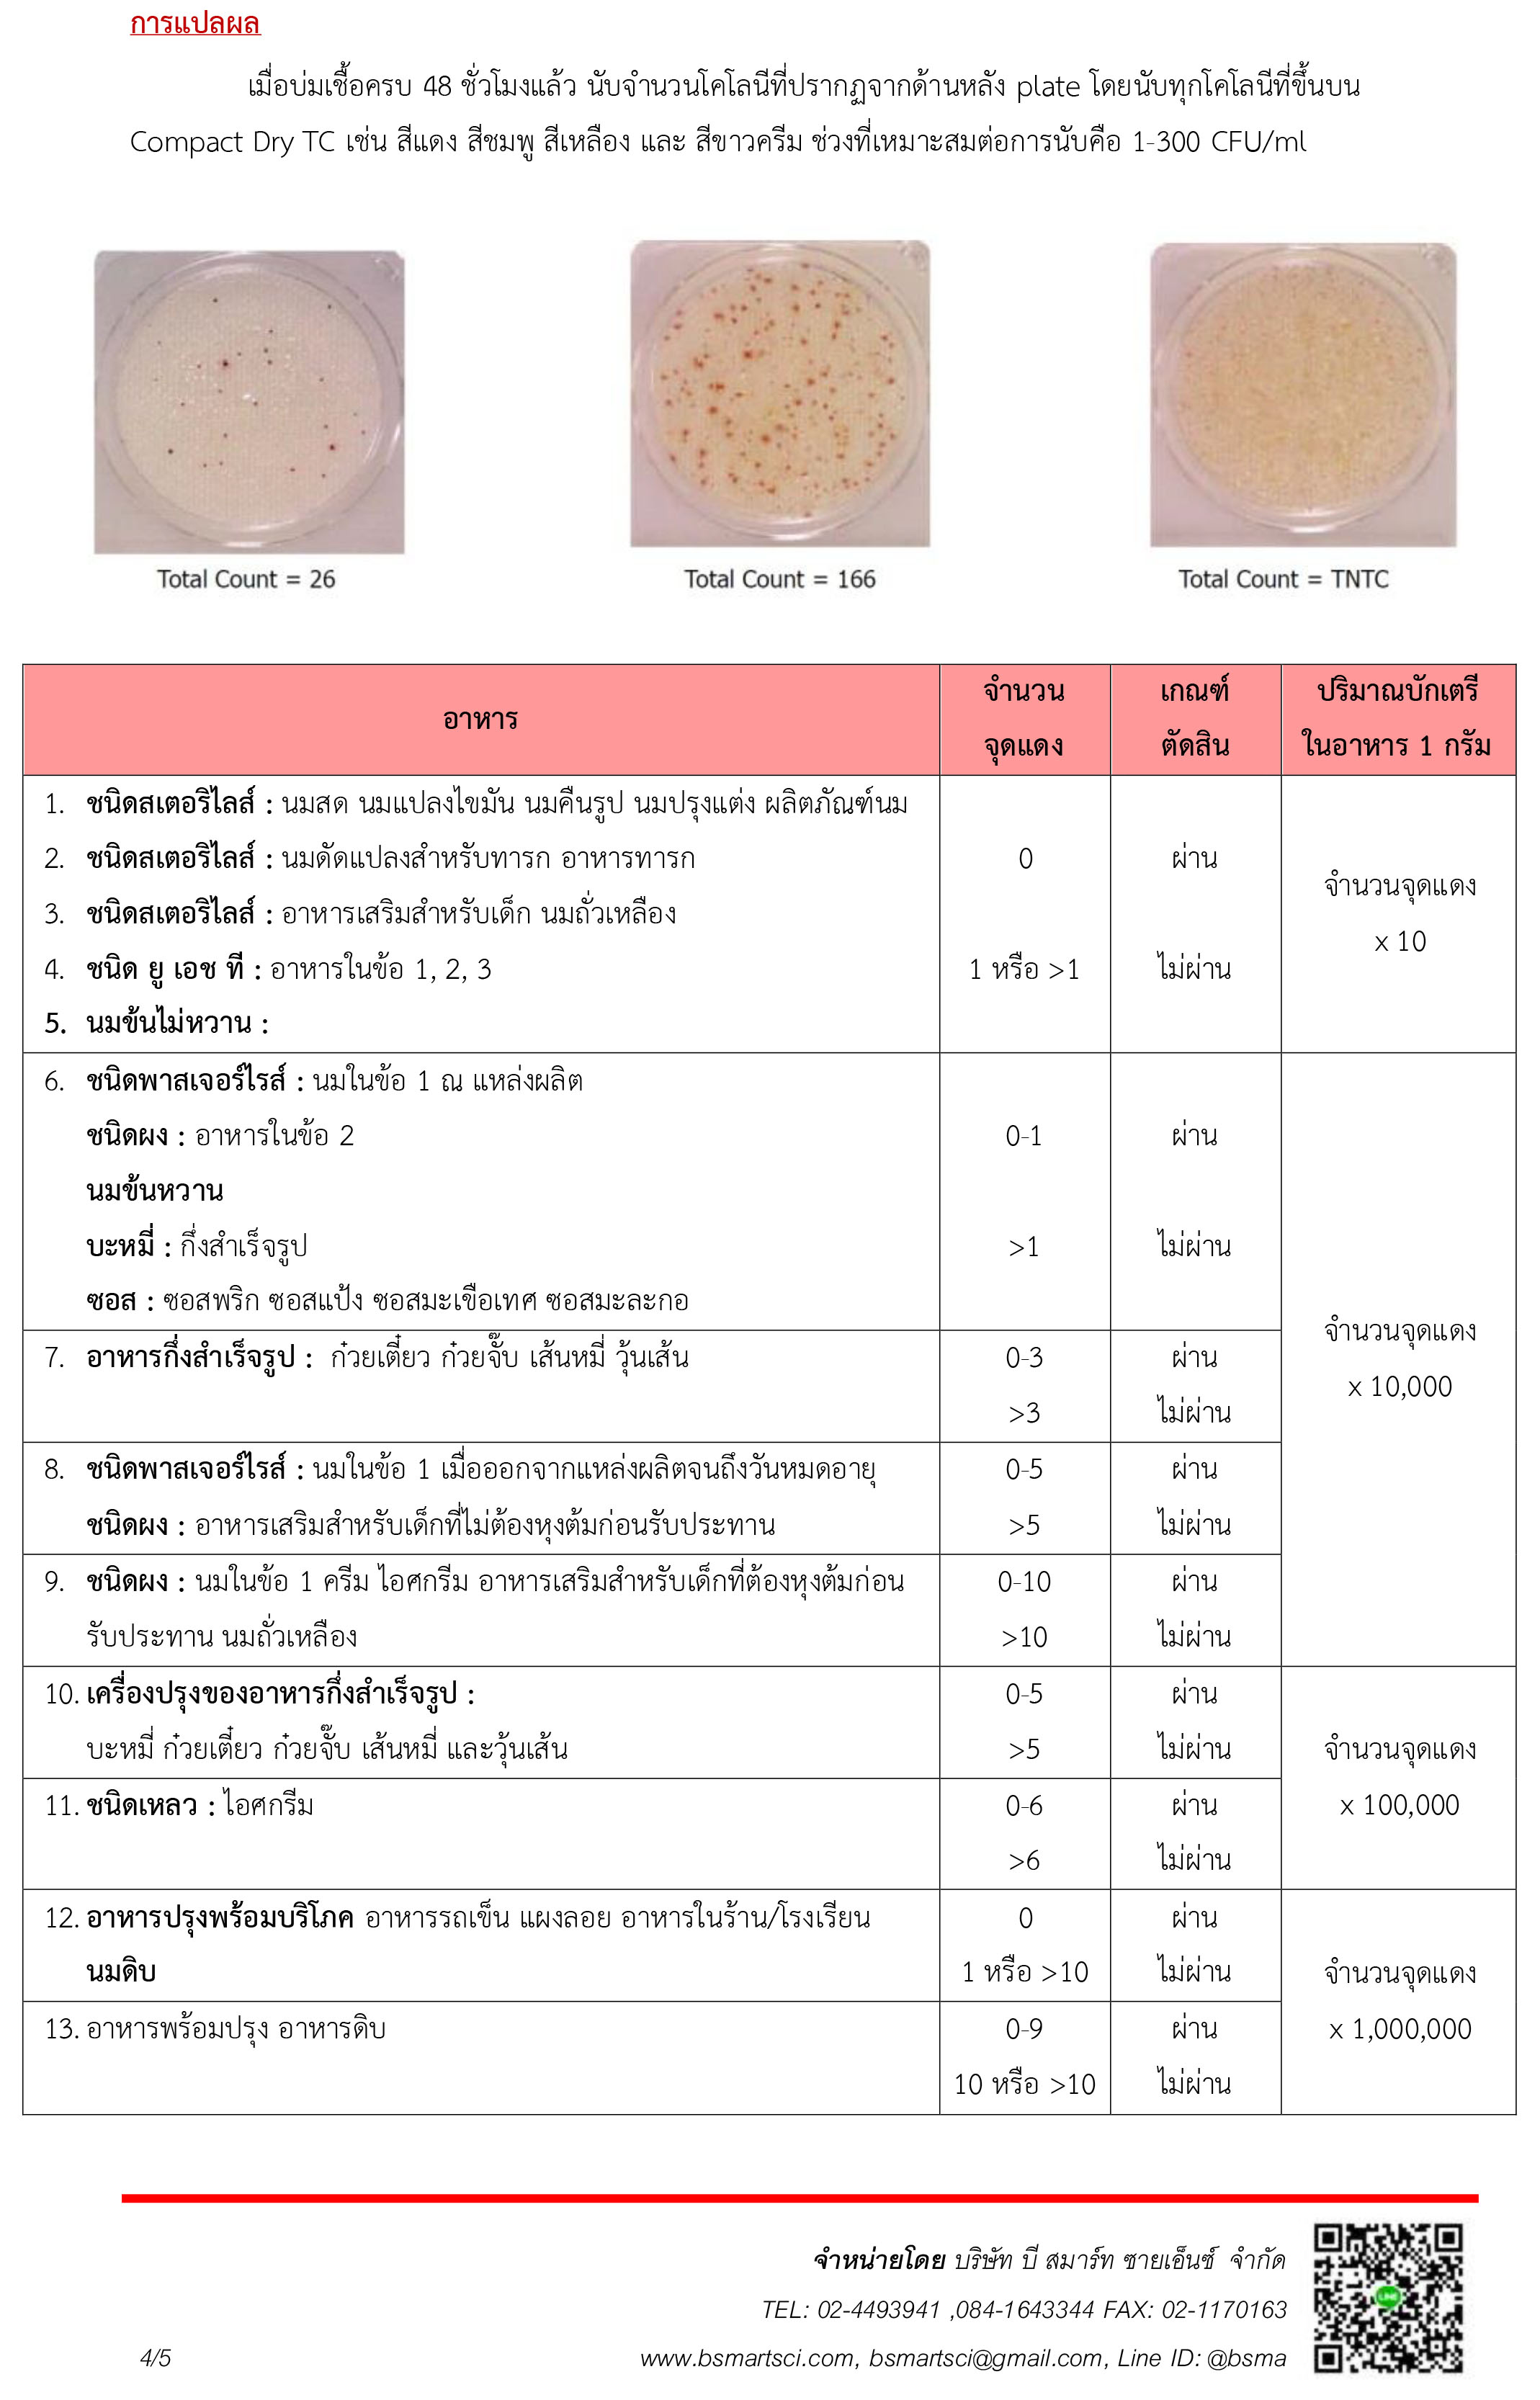

ชุดทดสอบปริมาณแบคทีเรียทั้งหมดในอาหาร (Compact Dry TC)
| จำนวน{{focus_pdata.unit}} | ส่วนลดต่อ{{focus_pdata.unit}} | ราคาสุทธิต่อ{{focus_pdata.unit}} |
| {{(typeof focus_pdata.price_list[idx+1] == 'undefined')?('≥ '+price_row.min_quantity):((price_row.min_quantity < (focus_pdata.price_list[idx+1].min_quantity - 1))?(price_row.min_quantity+' - '+(focus_pdata.price_list[idx+1].min_quantity - 1)):price_row.min_quantity)}} | {{number_format(((focus_pdata.price_old === null)?focus_pdata.price:focus_pdata.price_old) - price_row.price,2)}} บาท | {{number_format(price_row.price,2)}} บาท |
| คงเหลือ | ไม่จำกัด กล่อง |
| จำนวน (กล่อง) |
- +
|
|
ซื้อเลย หยิบลงตะกร้า ซื้อเลย หยิบลงตะกร้า คุณมีสินค้าชิ้นนี้ในตะกร้า 0 กล่อง
|
|
|
|
|
| คุยกับร้านค้า | |
| {{ size_chart_name }} |
|
| หมวดหมู่ | ชุดทดสอบอาหาร |
| สภาพ | สินค้าใหม่ |
| เพิ่มเติม | |
| สภาพ | สินค้ามือสอง |
| เกรด | |
| สถานะสินค้า | |
| ระยะเวลาจัดเตรียมสินค้า | |
| เข้าร่วมโปรโมชั่น | |
วิธีการส่งสินค้า
| สินค้า | ราคา (รวมvat) | เงื่อนไข |
| สินค้าปกติ |
107 บาท |
สั่งซื้อ 3,000 บาทขึ้นไปส่งฟรี |
| สินค้าแช่เย็น | 214 บาท |
ทุกคำสั่งซื้อ |
*สินค้าที่ต้องแช่เย็น เช่น ชุดทดสอบหายาฆ่าแมลง, ชุดทดสอบสารก่อภูมิแพ้ เป็นต้น ซึ่งจะมีระบุอยู่ที่เงื่อนไขอื่นๆด้านล่างหน้าสินค้านั้นนะคะ
*โปรดเลือกวิธีการส่งให้ตรงกับสินค้าที่ซื้อ มิฉะนั้นจะไม่สามารถทำการจัดส่งสินค้าให้ได้ค่ะ
รายละเอียดสินค้า
| ข้อมูล |
น้ำหนัก
บาร์โค้ด
ลงสินค้า
อัพเดทล่าสุด
|
||||
| รายละเอียดสินค้า |
ชุดทดสอบปริมาณแบคทีเรียทั้งหมดในอาหาร (12 TEST)โดยใช้ Compact Dry TC (Total plate count) เพลทอาหารชนิดสำเร็จรูปแบบแห้ง เพื่อนับจำนวนจุลินทรีย์ทั้งหมด
Compact Dry TC เป็นจานอาหารเลี้ยงเชื้อสำเร็จรูป สำหรับการตรวจหาจำนวนแบคทีเรียทั้งหมด ประกอบด้วยอาหารเลี้ยงเชื้อสำเร็จรูปแบบแห้ง non-selective medium และสารบ่งชี้ที่มีความจำเพาะเจาะจง redox indicator : 2,3,5-Triphenyl Tetrazolium Chloride (TTC) สามารถรายงานผลการทดสอบภายใน 48 ชั่วโมง ตัวอย่างเป้าหมาย
หมายเหตุ ชุดทดสอบนี้ใช้สำหรับตรวจคัดกรองและเฝ้าระวังเบื้องต้น หากพบข้อบ่งชี้ว่าอาจมีเชื้อในตัวอย่าง ควรส่งตรวจยืนยันกับทางห้องปฏิบัติการที่ได้มาตรฐานต่อไป การดูแลคุณภาพอาหารด้วยตนเอง
การรับประทานอาหารที่ไม่สะอาดเป็นสาเหตุของโรคทางเดินอาหาร ปริมาณบักเตรีที่ปนเปื้อนในอาหารสามารถบ่งชี้คุณภาพของอาหารได้ ดังนั้นกระทรวงสาธารณสุขจึงมีประกาศฯ ฉบับที่ 222 (พ.ศ. 2544), 265 (พ.ศ. 2545) ฯลฯ เพื่อกำหนดปริมาณบักเตรีในอาหาร อย่างไรก็ตามปัจจุบันยังตรวจพบปริมาณบักเตรีในอาหารที่สูงเกินมาตรฐาน จึงยังคงต้องตรวจสอบเพื่อความปลอดภัยต่อไป ผลกระทบต่อสุขภาพ |
||||
| เงื่อนไขอื่นๆ |
|
||||
| Tags |
วิธีการชำระเงิน
ชำระเงินผ่านธนาคาร
ชำระเงินด้วยการ Scan QR



นโยบายการเปลี่ยนหรือคืนสินค้า
- บริษัทฯ ยินดีรับเปลี่ยน/คืนสินค้า ภายใน 7 วันทำการนับตั้งแต่ลูกค้าเซ็นรับสินค้า หากเกินจากวันเวลาดังกล่าว บริษัทฯ ขอสงวนสิทธิ์ในการไม่รับเปลี่ยน/คืนสินค้า
- ทางบริษัทขอสงวนสิทธิ์ในการไม่รับเปลี่ยนสินค้าคืนทุกกรณี เช่น ลูกค้าไม่พึงพอใจในตัวผลิตภัณฑ์สินค้า ลูกค้าต้องการเปลี่ยนสินค้าข้ามรุ่น หรือลูกค้าสั่งซื้อสินค้าผิด
- ลูกค้าจะต้องถ่ายวิดิโอขณะแกะกล่องพัสดุ แบบคลิปเดียวจบ ไม่มีตัดต่อ หากไม่มีวิดิโอยืนยัน บริษัทฯ ขอสงวนสิทธิ์ในการไม่รับเปลี่ยน/คืนสินค้า
- ลูกค้าจะต้องทำการจัดส่งสินค้ากลับมายังบริษัทฯ โดยที่สินค้าที่ต้องการเปลี่ยน/คืนจะต้องอยู่ในสภาพสมบูรณ์ ไม่ชำรุดเสียหายจากการใช้งาน
- บริษัทฯ ขอสงวนสิทธิ์ในการพิจารณาตรวจสอบสภาพสินค้าที่ลูกค้าส่งกลับคืนมาก่อนจัดส่งสินค้าชิ้นใหม่ให้แก่ลูกค้า
- บริษัทฯ ขอสงวนสิทธิ์ในการรับเปลี่ยนสินค้าภายใต้นโยบายและเงื่อนไขตามที่บริษัทฯ กำหนดเท่านั้น
- สินค้าผิดรุ่น สินค้าผิดสี สินค้าไม่ตรงตามสเปค
- สินค้ามีสภาพชำรุด เสียหาย หรือไม่สามารถใช้งานได้ตั้งแต่ได้รับสินค้า
หากสินค้ามีปัญหากรุณาติดต่อมาที่ Line ID : @bsma หรือ โทร 02-4493941
Related to items you've viewed
Your recently viewed items
 บริษัท บี สมาร์ท ซายเอ็นซ์ จำกัด
บริษัท บี สมาร์ท ซายเอ็นซ์ จำกัด

อีเมล : bsmartsci@gmail.com
TOP เลื่อนขึ้นบนสุด




